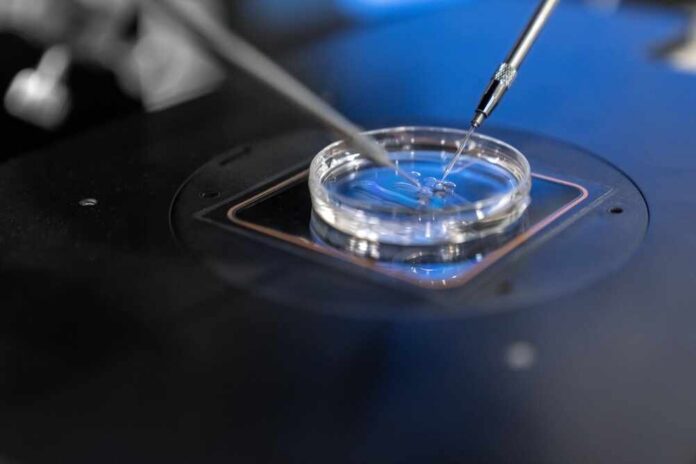
Close-up of a petri dish being manipulated with precision tools in a laboratory setting

A Florida couple’s journey through IVF turned into a nightmare when their newborn daughter proved genetically unrelated to them, exposing systemic failures in America’s unregulated fertility industry that leave families vulnerable to life-altering errors.
Story Snapshot
- White Florida couple gave birth to non-Caucasian baby via IVF, confirmed genetically unrelated through DNA testing
- Biological parents identified as “Patient Four” after court-ordered testing at Orlando fertility clinic
- Alleged embryo mix-up traces to 2020 mislabeling or 2025 transfer error spanning five years
- Case exposes absence of federal IVF oversight, relying only on state laws and clinic self-regulation
- Couple’s own embryos remain missing as lawsuit demands accountability from The Fertility Center of Orlando
Devastating Discovery Shatters IVF Dream
Tiffany Score and Steven Mills welcomed baby Shea on December 24, 2025, after undergoing embryo transfer at The Fertility Center of Orlando in April 2025. The newborn’s non-Caucasian appearance immediately raised concerns for the white couple. Genetic testing confirmed their worst fears with 99.9 percent accuracy: Shea shared no biological connection to either parent. The couple had endured multiple failed IVF rounds before this pregnancy, making the revelation particularly devastating. Their attorney Jack Scarola described the situation as “earthshattering,” capturing the profound emotional toll of discovering the child they carried and birthed belonged genetically to strangers.
Court-Ordered Testing Identifies Genetic Parents
The couple filed a lawsuit against The Fertility Center of Orlando and its operator IVF Life, demanding comprehensive testing and records disclosure covering the past five years. A judge ordered the clinic to provide free genetic testing for approximately 20 patients who underwent egg retrieval in March 2020 and those who received embryo transfers in April 2025. Multiple families came forward for testing. Recent developments confirmed the biological parents, identified confidentially as “Patient Four,” through DNA matching completed on a Tuesday following contact by the couple’s legal team. The identities remain protected, with Score and Mills pledging to respect their privacy while establishing communication channels.
Regulatory Void Enables Fertility Industry Failures
This incident highlights a critical weakness in American healthcare: the United States lacks federal regulation of IVF clinics, relying instead on a patchwork of state laws and voluntary clinic accreditation. This regulatory vacuum allows laboratories to operate without standardized tracking protocols, creating opportunities for catastrophic errors. The alleged mix-up potentially occurred during March 2020 egg retrieval or embryo creation, with the wrong embryo stored for five years before the April 2025 transfer. Previous incidents include a 2019 California case where a wrong embryo was implanted and a 2022 Missouri situation involving switched or discarded embryos. These precedents demonstrate recurring lab protocol failures without industry-wide corrective measures or accountability mechanisms.
Families Face Uncertain Future Amid Ongoing Investigation
Score and Mills publicly stated through attorney Scarola that they “will love and be this child’s parents forever,” yet acknowledged a moral obligation to the biological parents. The lawsuit continues as investigators work to determine whether the error stemmed from mislabeling in 2020 or mistakes during the 2025 transfer procedure. The couple remains unaware of what happened to their own embryos, adding another layer of anguish to their ordeal. The clinic has stated it is “actively cooperating” with the investigation, but the initial lack of responsiveness when the couple first raised concerns raises questions about institutional accountability. This case underscores how ordinary families seeking to build their lives through modern medicine become victims when profit-driven industries operate without adequate oversight, leaving parents to navigate legal battles while caring for children caught in bureaucratic failures beyond anyone’s control.
The broader implications extend beyond this single family. Trust in fertility services has eroded among clinic patients who now question whether their embryos are properly tracked and stored. The lawsuit seeks clinic funding for testing and disclosures, potentially setting precedents for IVF liability standards. Long-term consequences may include custody disputes, identity challenges for Shea as she grows older, and psychological impacts on all families involved. Florida lawmakers may face pressure to establish state-level IVF regulations, though without federal standards, Americans remain vulnerable to similar disasters. The case exemplifies how government failure to regulate specialized medical industries leaves citizens defenseless against institutional negligence that destroys dreams and fractures families.
Sources:
Couple says baby’s genetic parents identified in Florida IVF mix-up case – WFTV













